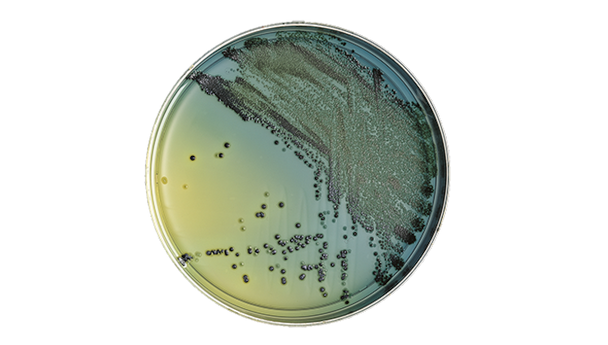
BD BBL Hektoen Enteric Agar Plate – Moderately Selective Medium, 100 Plates per Pack, 84-Day Shelf Life

Description
BD BBL Hektoen Enteric Agar Plate is designed for microbiology labs that need reliable isolation of enteric pathogens. When accuracy and efficiency matter, this prepared culture medium helps you streamline workflows and supports consistent results. Ideal for clinical and research settings focused on Salmonella and Shigella detection, thanks to its selective formulation.
- Moderately Selective Medium – Supports the isolation of Salmonella and Shigella species, giving you confidence in your results.
- High Lactose Content – Aids differentiation and minimizes delayed lactose fermentation, helping you work efficiently.
- Ready-to-Use Plates – Supplied in a 100-pack for convenience and reduced preparation time, so you stay focused on analysis.
- Consistent Shelf Life – 84-day shelf life supports inventory planning and peace of mind.
Prepared Culture Media for Reliable Pathogen Isolation
This selective agar plate is engineered for laboratories seeking dependable tools for enteric pathogen detection. The medium is formulated to isolate Salmonella and Shigella, with H2S-producing organisms yielding black-centered colonies for easy identification. The high lactose content aids in differentiating organisms and reduces the risk of delayed lactose fermentation. With a 100-plate pack and an 84-day shelf life, this product is well-suited for high-throughput clinical and research environments. Designed for microbiologists and lab technicians who require accuracy and efficiency in daily testing routines.
Features and Benefits
Selective Formulation
- Moderately Selective Medium – Isolates Salmonella and Shigella species, supporting targeted pathogen detection.
- High Lactose Level – Enhances differentiation of enteric organisms, improving workflow efficiency.
Convenient Packaging
- 100 Plates per Pack – Reduces the need for frequent reordering, supporting uninterrupted lab operations.
- Ready-to-Use Format – Saves time on media preparation, letting you focus on testing and analysis.
Reliable Performance
- 84-Day Shelf Life – Supports inventory management and ensures consistent availability.
Product Specifications
General Information
- Category: Prepared culture media
- Pack Size: 100 plates/pack
- Shelf Life: 84 days
Identification Codes
- SKU: 221366
- GTIN (Each): 00382902213666
- GTIN (Shelfpack): 30382902213667
- GTIN (Bag): 10382902213663
- GTIN (US Standard Pallet): 60382902213668
Explore More: See all Prepared Culture Media | Shop more BD BBL Products
Consistent Results and Efficient Lab Operations
Choose this selective agar plate for dependable performance in clinical and research labs. The ready-to-use format and long shelf life help you maintain a steady workflow and reduce downtime. You get the reassurance of a product designed for accuracy and ease of use, supporting your team’s confidence in every test.
- Targeted Pathogen Isolation – Supports detection of Salmonella and Shigella, helping labs meet diagnostic needs.
- Time-Saving Convenience – 100-pack format reduces preparation and ordering frequency, streamlining lab routines.
- Inventory Planning – 84-day shelf life makes stock management easier and more predictable.
- Trusted Brand – Manufactured by BD BBL, a recognized name in laboratory media.
Frequently Asked Questions (FAQs)
What organisms is this agar plate designed to isolate?
This medium is formulated for the isolation of Salmonella and Shigella species.
How many plates come in each pack?
Each pack contains 100 ready-to-use agar plates.
What is the shelf life of this product?
The shelf life is 84 days, supporting efficient inventory management.
Does this medium help differentiate between organisms?
Yes, the high lactose content aids in differentiating enteric organisms and minimizes delayed lactose fermentation.
Is this product suitable for clinical and research labs?
Yes, it is designed for both clinical and research laboratory environments focused on enteric pathogen detection.
What is the main advantage of the ready-to-use format?
The ready-to-use plates save time on preparation and support consistent testing routines.
Who manufactures this agar plate?
This product is manufactured by BD BBL, a trusted provider of laboratory media.